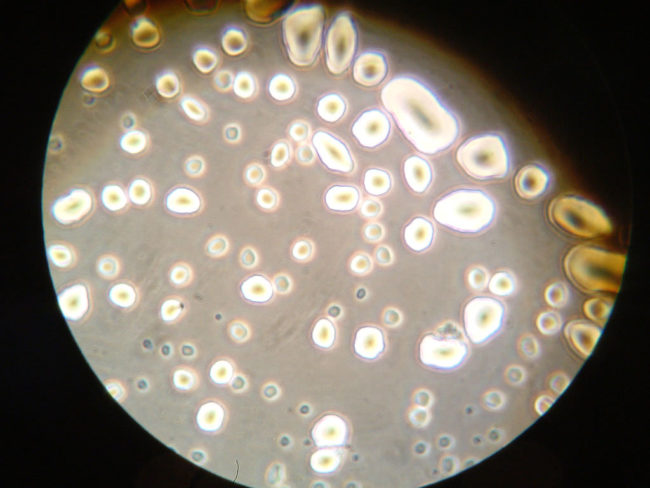

★公众号:寰宇科学(点击复制)微信
太阳消失后地球会发生的12件事,缓慢的死亡比灭绝还惨
2018-7-10 寰宇科学
你有没有想过,如果太阳消失了会发生什么事吗?你猜对了,一定不会有什么好事。太阳研究中心很好奇到底会发生什么事,所以他们制作了一个稍微有点可怕的时间推测。如果没有太阳的话,随着时间推移,到底会发生什么事?
1. 八分钟后,行星将停止绕行轨道,因为失去太阳引力了。他们都只会以一条直线的型态在太空中移动。

2. 一分钟后,我们被黑暗吞噬。

3. 星星还是闪亮的,但没有太阳反射的月亮,我们将再也看不到月光了。

4. 再过几天,地球温度将开始下降。几个月后会达到摄氏负87度,4个月后到达摄氏负162度。

5. 大多数细菌会在几天之内死亡,但是一些微生物可能仍然能够生存在地球表面。
6. 我们很有可能一个月内死亡,但是如果我们躲在封闭的地方,或是深海中的浅水艇,就有可能存活。

7. 植物可以存活几周,但缺乏太阳就无法进行光合作用了。食草动物会在没有食物来源后死亡。

8. 食腐动物会活得久一点,因为他们靠吃动物尸体,但是没有食物来源也就开始死亡。

9. 海洋的表面会在两个月左右结冰,生活在海底的生物可以活得久一点。

10. 并不是所有生物都会在早期灭绝,大树可以存活数十年。

11. 海洋的冰冻层会把海洋跟空气隔绝,使海洋几千年内也不会完全结冰。

12.当地球完全冰冻达到摄氏负204度时,大气层也会崩解,因此无法再保护地球防止宇宙射线的侵害了。

太阳在太阳系中扮演着极重要的角色,有天如果真的没有太阳了,地球的生物也会随之灭亡。

共有376阅 / 0评我要评论
发表你的评论吧返回顶部
!评论内容需包含中文
